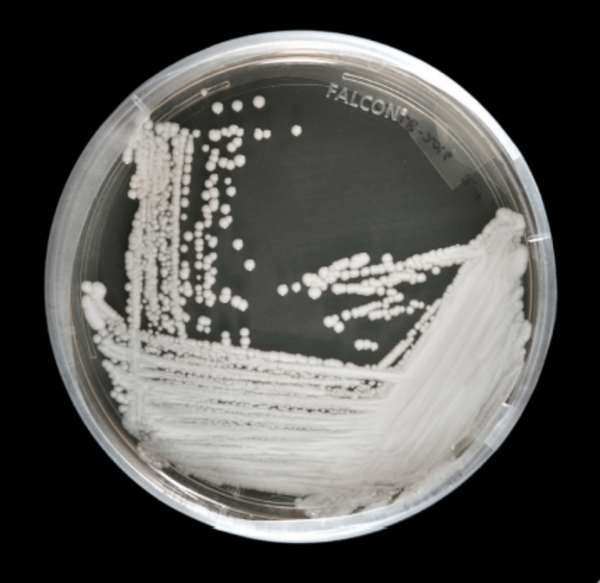
Hong Kong Reports Dramatic Spike in Deadly Superbug Cases Amid COVID-19 Pandemic - Sputnik International

Dr. Raymond Lai, the chief infection control officer of Hong Kong’s Hospital Authority, revealed Friday that officials are attempting to find an explanation for the worrying outbreak of some 136 reported cases of Candida auris within a 10-month span.
Comparatively, 20 cases of the deadly fungal infection were logged for all of 2019.
“We hope to control the fungus within the hospitals and elderly homes, so it won’t be spread to the community,” Lai said during an October 23 news conference, as reported by the South China Morning Post.
Depending on the infection’s location and an individual’s health, patients with the superbug are said to have between a 30% and 60% chance of death, according to the US Centers for Disease Control and Prevention.
Furthermore, scientists have found that, in some infectees, yeast resistant to commonly used antifungal drugs can enter the bloodstream, causing life-threatening and invasive infections throughout the body.
Many identified Candida auris cases originated in senior homes and hospitals, including Yan Chai Hospital, Princess Margaret Hospital and North Lantau Hospital. Infections have been reported in patients with ages ranging from 21 to 101, but almost 80% of all cases were found in people aged over 60 years old.
Lai believes the COVID-19 pandemic has contributed to the spread of the fungal infection due to the lack of available isolation facilities in Hong Kong’s public hospitals.
Experts have identified that, like the novel coronavirus, Candida auris can spread via contact with a contaminated surface, or through person-to-person contact.
“Some hospitals don’t have isolation rooms in their general wards, so they can only put Candida auris patients at the corner of these wards as a precautionary measure, which can increase chances of cross infection,” Lai explained.
“Currently the patients need to share medical equipment, but we aim to have separate equipment for every single patient and prevent cross infection between them,” he stated.
The health expert did not reveal how many fatalities, if any, have been associated with the superbug this year.